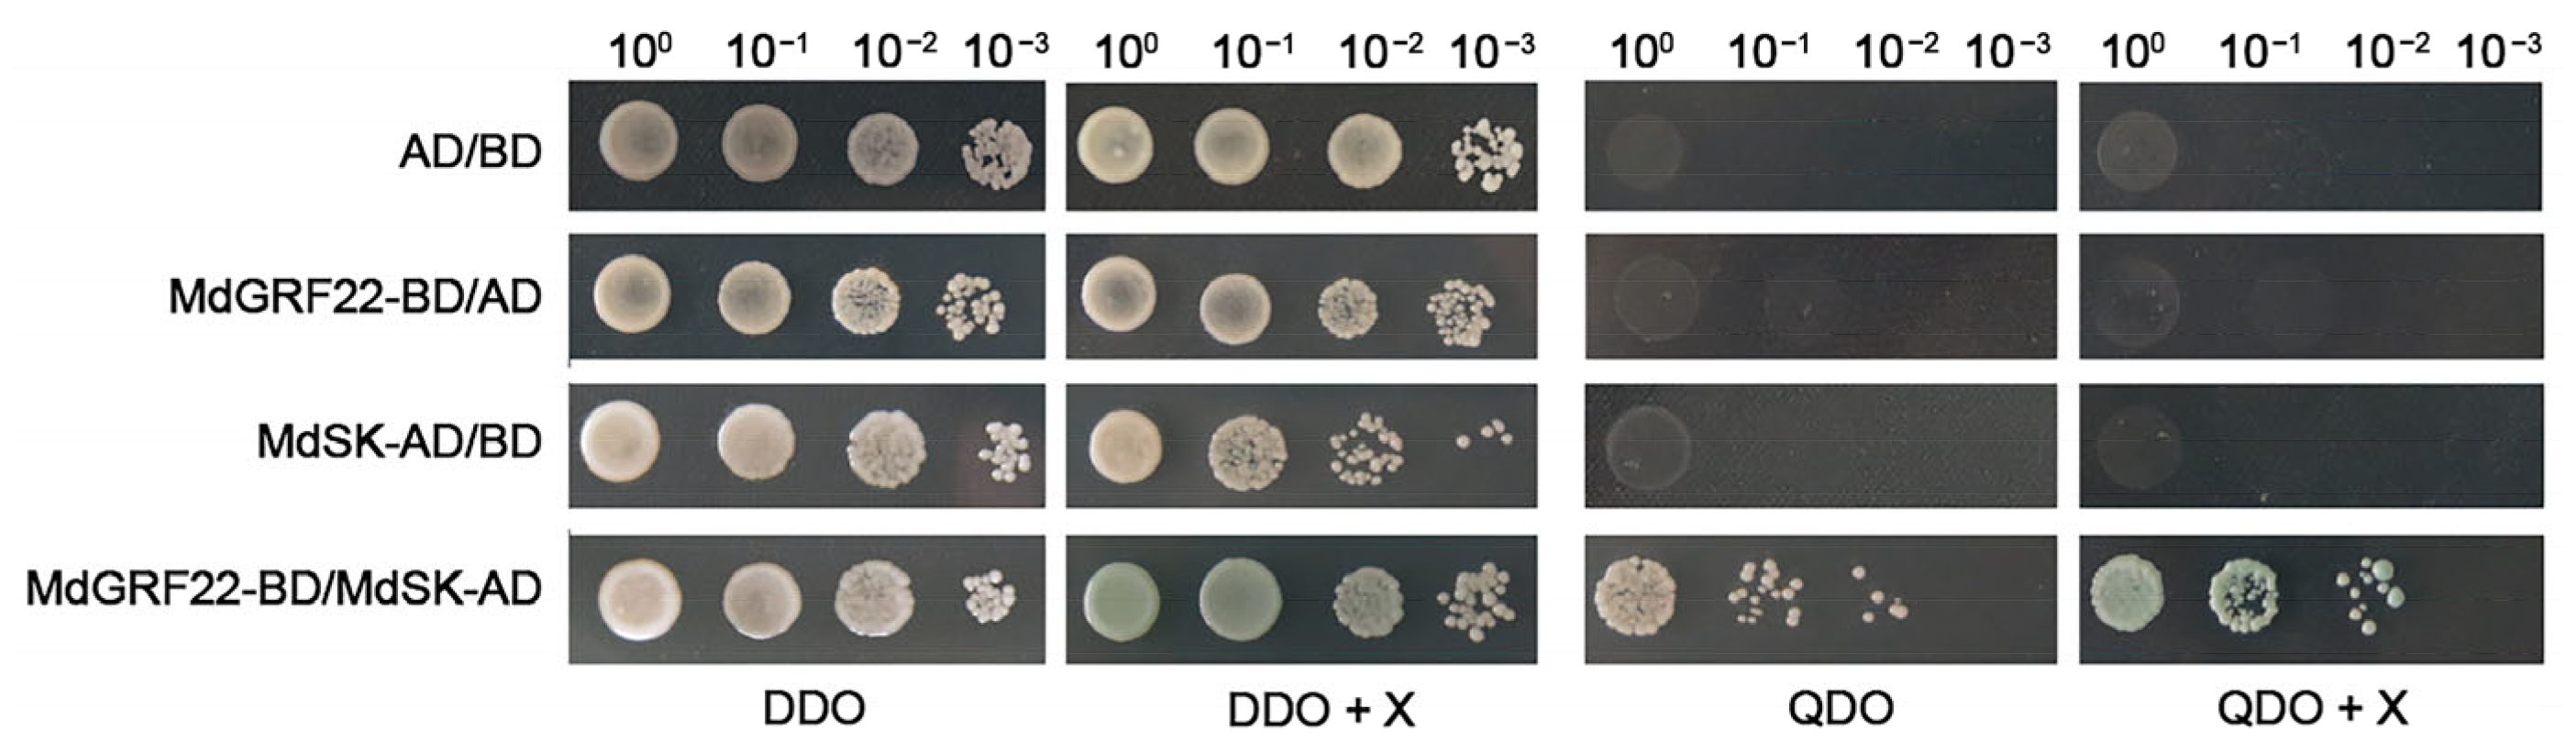
Plants 14 01968 g003

MdGRF22, a 14-3-3 Family Gene in Apple, Negatively Regulates Drought Tolerance via Modulation of Antioxidant Activity and Interaction with MdSK
Abstract
1. Introduction
2. Results
2.1. Sequence Alignment of MdGRF22 and Homologous Genes
2.2. Quantitative Real-Time PCR (qRT-PCR) and Subcellular Localization Analysis of MdGRF22 Gene in Apple
2.3. Y2H Analysis of MdGRF22 Protein
2.4. Overexpression of MdGRF22 Reduced Drought Tolerance in Transgenic A. thaliana
2.5. Overexpression of MdGRF22 Reduced Drought Tolerance in Transgenic Apple Callus
3. Discussion
4. Materials and Methods
4.1. Sequence and Structure Analysis of MdGRF22
4.2. Plant Materials and Treatment
4.3. qRT-PCR Analysis of MdGRF22 Gene
4.4. Cloning and Transformation
4.5. Subcellular Localization of MdGRF22 Protein
4.6. Y2H Analysis
4.7. Generation of MdGRF22 Transgenic A. thaliana and Apple Callus
4.8. Identification of the MdGRF22 Transgenic A. thaliana and Callus
4.9. Treatment and Determination of Related Physiological Indexes in A. thaliana and Callus
4.10. Statistical Analysis
5. Conclusions
Supplementary Materials
Author Contributions
Funding
Data Availability Statement
Acknowledgments
Conflicts of Interest
References
- Han, X.; Wang, J.; Zhang, L. Coordination of Hydraulic and Leaf-level Gas Exchange Traits during Water-deficit Acclimation in Apple Rootstocks. Physiol. Plant. 2023, 175, e14037. [Google Scholar] [CrossRef] [PubMed]
- Kopecká, R.; Kameniarová, M.; Černý, M.; Brzobohatý, B.; Novák, J. Abiotic Stress in Crop Production. Int. J. Mol. Sci. 2023, 24, 6603. [Google Scholar] [CrossRef]
- Liu, W.; Chen, Z.; Jiang, S.; Wang, Y.; Fang, H.; Zhang, Z.; Chen, X.; Wang, N. Research Progress on Genetic Basis of Fruit Quality Traits in Apple (Malus × domestica). Front. Plant Sci. 2022, 13, 918202. [Google Scholar] [CrossRef]
- Aitken, A. 14-3-3 Proteins: A Historic Overview. Semin. Cancer Biol. 2006, 16, 162–172. [Google Scholar] [CrossRef] [PubMed]
- Huang, Y.; Wang, W.; Yu, H.; Peng, J.; Hu, Z.; Chen, L. The Role of 14-3-3 Proteins in Plant Growth and Response to Abiotic Stress. Plant Cell Rep. 2022, 41, 833–852. [Google Scholar] [CrossRef]
- Aducci, P.; Camoni, L.; Marra, M.; Visconti, S. From Cytosol to Organelles: 14-3-3 Proteins as Multifunctional Regulators of Plant Cell. IUBMB Life 2002, 53, 49–55. [Google Scholar] [CrossRef] [PubMed]
- Waese, J.; Fan, J.; Pasha, A.; Yu, H.; Fucile, G.; Shi, R.; Cumming, M.; Kelley, L.A.; Sternberg, M.J.; Krishnakumar, V.; et al. ePlant: Visualizing and Exploring Multiple Levels of Data for Hypothesis Generation in Plant Biology. Plant Cell 2017, 29, 1806–1821. [Google Scholar] [CrossRef]
- Chevalier, D.; Morris, E.R.; Walker, J.C. 14-3-3 and FHA Domains Mediate Phosphoprotein Interactions. Annu. Rev. Plant Biol. 2009, 60, 67–91. [Google Scholar] [CrossRef]
- Mareri, L.; Parrotta, L.; Cai, G. Environmental Stress and Plants 2.0. Int. J. Mol. Sci. 2022, 23, 5416. [Google Scholar] [CrossRef]
- Yang, L.; You, J.; Wang, Y.; Li, J.; Quan, W.; Yin, M.; Wang, Q.; Chan, Z. Systematic Analysis of the G-box Factor 14-3-3 Gene Family and Functional Characterization of GF14a in Brachypodium distachyon. Plant Physiol. Biochem. 2017, 117, 1–11. [Google Scholar] [CrossRef]
- Sun, X.; Luo, X.; Sun, M.Z.; Chen, C.; Ding, X.D.; Wang, X.D.; Yang, S.S.; Yu, Q.Y.; Jia, B.W.; Cai, H.; et al. A Glycine soja 14-3-3 Protein GsGF14o Participates in Stomatal and Root Hair Development and Drought Tolerance in Arabidopsis thaliana. Plant Cell Physiol. 2014, 55, 99–118. [Google Scholar] [CrossRef] [PubMed]
- Ren, Y.R.; Yang, Y.Y.; Zhang, R.; You, C.; Zhao, Q.; Hao, Y. MdGRF11, an Apple 14-3-3 Protein, Acts as a Positive Regulator of Drought and Salt Tolerance. Plant Sci. 2019, 288, 110219. [Google Scholar] [CrossRef]
- Jiang, L.; Lv, J.; Li, K.; Zhai, L.; Wu, Y.; Wu, T.; Zhang, X.; Han, Z.; Wang, Y. MdGRF11-MdARF19-2 Module Acts as a Positive Regulator of Drought Resistance in Apple Rootstock. Plant Sci. 2023, 335, 111782. [Google Scholar] [CrossRef]
- Woodgett, J.R. A Common Denominator Linking Glycogen Metabolism, Nuclear Oncogenes and Development. Trends Biochem. Sci. 1991, 16, 177–181. [Google Scholar] [CrossRef]
- Li, C.; Zhang, B.; Yu, H. GSK3s: Nodes of Multilayer Regulation of Plant Development and Stress Responses. Trends Plant Sci. 2021, 26, 1286–1300. [Google Scholar] [CrossRef]
- Jiang, H.; Tang, B.; Xie, Z.; Nolan, T.; Ye, H.; Song, G.Y.; Walley, J.W. GSK3-like Kinase BIN2 Phosphorylates RD26 to Potentiate Drought Signaling in Arabidopsis. Plant J. 2019, 100, 923–937. [Google Scholar] [CrossRef] [PubMed]
- Xie, Z.; Nolan, T.; Jiang, H.; Tang, B.; Zhang, M.; Li, Z.; Yin, Y. The AP2/ERF Transcription Factor TINY Modulates Brassinosteroid-regulated Plant Growth and Drought Responses in Arabidopsis. Plant Cell 2019, 31, 1788–1806. [Google Scholar] [CrossRef]
- Ren, J.X.; Li, Y.M.; Ma, W.F.; Wu, Z.; Mao, J. Identification of Apple 14-3-3 Gene Family and Functional Analysis of MdGRF13 Gene in Apple. J. Fruit Sci. 2023, 40, 405–421. [Google Scholar]
- Zhao, P.; Zhao, C.; Chen, D.; Yun, C.; Li, H.; Bai, L. Structure and Activation Mechanism of the Hexameric Plasma Membrane H⁺-ATPase. Nat. Commun. 2021, 12, 6439. [Google Scholar] [CrossRef]
- Avise, J.C. Evolutionary Pathways in Nature: A Phylogenetic Approach. Choice Rev. Online 2006, 44, 44–1508. [Google Scholar]
- Baum, D.A.; Offner, S. Phylogenies and Tree Thinking. Am. Biol. Teach. 2008, 70, 222–229. [Google Scholar] [CrossRef]
- Mofatteh, M.; Bullock, S.L. SnapShot: Subcellular mRNA Localization. Cell 2017, 169, 178. [Google Scholar] [CrossRef]
- Fan, B.; Liao, K.; Wang, L.N.; Shi, L.; Zhang, Y.; Xu, L.; Zhou, Y.; Li, J.; Chen, Y.; Chen, Q.; et al. Calcium-dependent Activation of CPK12 Facilitates its Cytoplasm-to-nucleus Translocation to Potentiate Plant Hypoxia Sensing by Phosphorylating ERF-VII Transcription Factors. Mol. Plant 2023, 16, 979–998. [Google Scholar] [CrossRef] [PubMed]
- Zuo, X.; Wang, S.; Xiang, W.; Yang, H.; Tahir, M.M.; Zheng, S.; An, N.; Han, M.; Zhao, C.; Zhang, D. Genome-wide Identification of the 14-3-3 Gene Family and Its Participation in Floral Transition by Interacting with TFL1/FT in Apple. BMC Genom. 2021, 22, 1–17. [Google Scholar] [CrossRef] [PubMed]
- Jia, C.; Guo, B.; Wang, B.; Li, X.; Yang, T.; Li, N.; Wang, J.; Yu, Q. Genome-wide Identification and Expression Analysis of the 14-3-3 (TFT) Gene Family in Tomato, and the Role of SlTFT4 in Salt Stress. Plants 2022, 11, 3491. [Google Scholar] [CrossRef]
- Kiriyama, H.; Kinoshita, S.N.; Hayashi, Y.; Honda, R.; Kasuga, S.; Kinoshita, T.; Irieda, H.; Ohkanda, J. Fungal Toxin Fusicoccin Enhances Plant Growth by Upregulating 14-3-3 Interaction with Plasma Membrane H⁺-ATPase. Sci. Rep. 2024, 14, 23431. [Google Scholar] [CrossRef]
- Roberts, M.R. 14-3-3 Proteins Find New Partners in Plant Cell Signalling. Trends Plant Sci. 2003, 8, 218–223. [Google Scholar] [CrossRef]
- DeLille, J.M.; Sehnke, P.C.; Ferl, J. The Arabidopsis 14-3-3 Family of Signaling Regulators. Plant Physiol. 2001, 126, 35–38. [Google Scholar] [CrossRef]
- Hirsch, S.; Aitken, A.; Bertsch, U.; Soll, J. A Plant Homologue to Mammalian Brain 14-3-3 Protein and Protein Kinase C Inhibitor. FEBS Lett. 1992, 296, 222–224. [Google Scholar] [CrossRef]
- Shin, R.; Jez, J.M.; Basra, A.; Zhang, B.; Schachtman, D.P. 14-3-3 Proteins Fine-tune Plant Nutrient Metabolism. FEBS Lett. 2011, 585, 143–147. [Google Scholar] [CrossRef]
- Ormancey, M.; Thuleau, P.; Mazars, C.; Cotelle, V. CDPKs and 14-3-3 Proteins: Emerging Duo in Signaling. Trends Plant Sci. 2017, 22, 263–272. [Google Scholar] [CrossRef]
- Wang, L.; Yang, Z.; Zhang, B.; Yu, D.; Liu, J.; Gong, Q.; Qanmber, G.; Li, Y.; Lu, L.; Lin, Y.; et al. Genome-wide Characterization and Phylogenetic Analysis of GSK Gene Family in Three Species of Cotton: Evidence for a Role of Some GSKs in Fiber Development and Responses to Stress. BMC Plant Biol. 2018, 18, 330. [Google Scholar] [CrossRef] [PubMed]
- Christov, N.; Christova, P.; Kato, H.; Liu, Y.; Sasaki, K.; Imai, R. TaSK5, an Abiotic Stress-inducible GSK3/shaggy-like Kinase from Wheat, Confers Salt and Drought Tolerance in Transgenic Arabidopsis. Plant Physiol. Biochem. 2014, 84, 251–260. [Google Scholar] [CrossRef]
- Hu, F.; Chen, M.; Zhang, Y.; Wang, T.; Li, R. Molecular Characterization and Expression Patterns of Shaggy-related Kinase (MmSK) Gene of Mulberry (Morus multicaulis). Russ. J. Bioorg. Chem. 2022, 46, 768–777. [Google Scholar]
- Abarca, D.; Madueño, F.; Martínez-Zapater, J.M.; Salinas, J. Dimerization of Arabidopsis 14-3-3 Proteins: Structural Requirements within the N-terminal Domain and Effect of Calcium. FEBS Lett. 1999, 462, 377–382. [Google Scholar] [CrossRef]
- Duscha, K.; Rodrigues, C.M.; Muller, M.; Wartenberg, R.; Fliegel, L.; Deitmer, J.W.; Jung, M.; Zimmermann, R.; Neuhaus, H.E. 14-3-3 Proteins and Other Candidates Form Protein-protein Interactions with the Cytosolic C-terminal End of SOS1 Affecting its Transport Activity. Int. J. Mol. Sci. 2020, 21, 3334. [Google Scholar] [CrossRef] [PubMed]
- Paul, A.L.; Denison, F.C.; Schultz, E.R.; Zupanska, A.K.; Ferl, R.J. 14-3-3 Phosphoprotein Interaction Networks-Does Isoform Diversity Present Functional Interaction Specification? Front. Plant Sci. 2012, 3, 190. [Google Scholar] [CrossRef]
- Jiang, W.; He, J.; Babla, M.; Wu, T.; Tong, T.; Riaz, A.; Zeng, F.; Qin, Y.; Chen, G.; Deng, F.; et al. Molecular Evolution and Interaction of 14-3-3 Proteins with H⁺-ATPases in Plant Abiotic Stresses. J. Exp. Bot. 2023, 75, 689–707. [Google Scholar] [CrossRef] [PubMed]
- Chen, Y.; Zhou, X.; Chang, S.; Chu, Z.; Wang, H.; Han, S.; Wang, Y. Calcium-dependent Protein Kinase 21 Phosphorylates 14-3-3 Proteins in Response to ABA Signaling and Salt Stress in Rice. Biochem. Biophys. Res. Commun. 2017, 493, 1450–1456. [Google Scholar] [CrossRef]
- Sarma, B.; Kashtoh, H.; Tamang, T.L.; Bhattacharyya, P.N.; Mohanta, Y.K.; Baek, K.H. Abiotic Stress in Rice: Visiting the Physiological Response and Its Tolerance Mechanisms. Plants 2023, 12, 3948. [Google Scholar] [CrossRef]
- Tiwari, J.K.; Munshi, A.D.; Kumar, R.; Pandey, R.N.; Arora, A.; Bhat, J.S.; Sureja, A.K. Effect of Salt Stress on Cucumber: Na⁺/K⁺ Ratio, Osmolyte Concentration, Phenols and Chlorophyll Content. Acta Physiol. Plant. 2010, 32, 103–114. [Google Scholar] [CrossRef]
- Pathare, V.; Srivastava, S.; Sonawane, B.V.; Suprasanna, P. Arsenic Stress Affects the Expression Profile of Genes of 14-3-3 Proteins in the Shoot of Mycorrhiza Colonized Rice. Physiol. Mol. Biol. Plants 2016, 22, 515–522. [Google Scholar] [CrossRef]
- Campo, S.; Peris-Peris, C.; Montesinos, L.; Peñas, G.; Messeguer, J.; San Segundo, B. Expression of the Maize ZmGF14-6 Gene in Rice Confers Tolerance to Drought Stress While Enhancing Susceptibility to Pathogen Infection. J. Exp. Bot. 2012, 63, 983–999. [Google Scholar] [CrossRef]
- Liu, J.; Sun, X.; Liao, W.; Zhang, J.; Liang, J.; Xu, W. Involvement of OsGF14b Adaptation in the Drought Resistance of Rice Plants. Rice 2019, 12, 82. [Google Scholar] [CrossRef] [PubMed]
- Adnan, M.; Morton, G.; Hadi, S. Analysis of rpoS and bolA Gene Expression under Various Stress-induced Environments in Planktonic and Biofilm Phase Using 2−ΔΔCT Method. Mol. Cell. Biochem. 2011, 357, 275–282. [Google Scholar] [CrossRef] [PubMed]
- Zheng, L.; Yao, J.; Gao, F.; Lin, C.; Zhang, C.; Lian, L.; Xie, L.; Wu, Z.; Xie, L. The Subcellular Localization and Functional Analysis of Fibrillarin2, a Nucleolar Protein in Nicotiana benthamiana. BioMed Res. Int. 2016, 2016, 2831287. [Google Scholar] [CrossRef] [PubMed]
- Zhang, T.; Kang, H.; Fu, L.; You, C.; Wang, X.; Hao, Y. Expression Analysis of Apple MdCYP707A Family Genes and Functional Characterization of MdCYP707A1. Acta Hortic. Sin. 2022, 46, 1429–1444. [Google Scholar]
- Yang, L. Functional Analysis of Apple Plasma Membrane Intrinsic Protein Genes MdPIP1;1 and MdPIP1;2 under Drought and Salt Stress. Master’s Thesis, North West Agriculture and Forestry University, Xianyang, China, 2020. [Google Scholar]
- Jha, R.K.; Mishra, A. Introgression of SbERD4 Gene Encodes an Early-responsive Dehydration-stress Protein that Confers Tolerance Against Different Types of Abiotic Stresses in Transgenic Tobacco. Cells 2021, 11, 62. [Google Scholar] [CrossRef]

Disclaimer/Publisher’s Note: The statements, opinions and data contained in all publications are solely those of the individual author(s) and contributor(s) and not of MDPI and/or the editor(s). MDPI and/or the editor(s) disclaim responsibility for any injury to people or property resulting from any ideas, methods, instructions or products referred to in the content. |
© 2025 by the authors. Licensee MDPI, Basel, Switzerland. This article is an open access article distributed under the terms and conditions of the Creative Commons Attribution (CC BY) license (https://creativecommons.org/licenses/by/4.0/).
Share and Cite
Ren, J.; Wang, H.; Zhao, M.; Liang, G.; Lu, S.; Mao, J. MdGRF22, a 14-3-3 Family Gene in Apple, Negatively Regulates Drought Tolerance via Modulation of Antioxidant Activity and Interaction with MdSK. Plants 2025, 14, 1968. https://doi.org/10.3390/plants14131968
Ren J, Wang H, Zhao M, Liang G, Lu S, Mao J. MdGRF22, a 14-3-3 Family Gene in Apple, Negatively Regulates Drought Tolerance via Modulation of Antioxidant Activity and Interaction with MdSK. Plants. 2025; 14(13):1968. https://doi.org/10.3390/plants14131968
Chicago/Turabian StyleRen, Jiaxuan, Hong Wang, Mingxin Zhao, Guoping Liang, Shixiong Lu, and Juan Mao. 2025. "MdGRF22, a 14-3-3 Family Gene in Apple, Negatively Regulates Drought Tolerance via Modulation of Antioxidant Activity and Interaction with MdSK" Plants 14, no. 13: 1968. https://doi.org/10.3390/plants14131968
APA StyleRen, J., Wang, H., Zhao, M., Liang, G., Lu, S., & Mao, J. (2025). MdGRF22, a 14-3-3 Family Gene in Apple, Negatively Regulates Drought Tolerance via Modulation of Antioxidant Activity and Interaction with MdSK. Plants, 14(13), 1968. https://doi.org/10.3390/plants14131968
